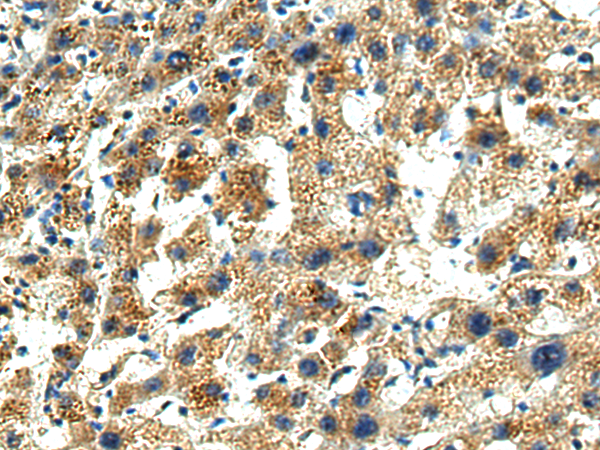

中文名稱:兔抗CASP1多克隆抗體
英文名稱: Anti-CASP1 rabbit polyclonal antibody
別 名: ICE, P45, IL1BC
相關類別: 一抗
抗 原: CASP1
儲 存: 冷凍(-20℃)
宿 主: Rabbit
反應種屬: Human
標 記 物: Unconjugate
克隆類型: rabbit polyclonal
技術規格
| Background: | This gene encodes a protein which is a member of the cysteine-aspartic acid protease (caspase) family. Sequential activation of caspases plays a central role in the execution-phase of cell apoptosis. Caspases exist as inactive proenzymes which undergo proteolytic processing at conserved aspartic residues to produce 2 subunits, large and small, that dimerize to form the active enzyme. This gene was identified by its ability to proteolytically cleave and activate the inactive precursor of interleukin-1, a cytokine involved in the processes such as inflammation, septic shock, and wound healing. This gene has been shown to induce cell apoptosis and may function in various developmental stages. Studies of a similar gene in mouse suggest a role in the pathogenesis of Huntington disease. Alternative splicing results in transcript variants encoding distinct isoforms. |
| Applications: | ELISA, WB, IHC |
| Name of antibody: | CASP1 |
| Immunogen: | Fusion protein of human CASP1 |
| Full name: | caspase 1 |
| Synonyms: | ICE; P45; IL1BC |
| SwissProt: | P29466 |
| ELISA Recommended dilution: | 5000-10000 |
| IHC positive control: | Human liver cancer |
| IHC Recommend dilution: | 200-300 |
| WB Predicted band size: | 45 kDa |
| WB Positive control: | Mouse brain tissue, Jurkat cell, 293T cell lysates |
| WB Recommended dilution: | 1000-5000 |

購物車
幫助
021-54845833/15800441009
